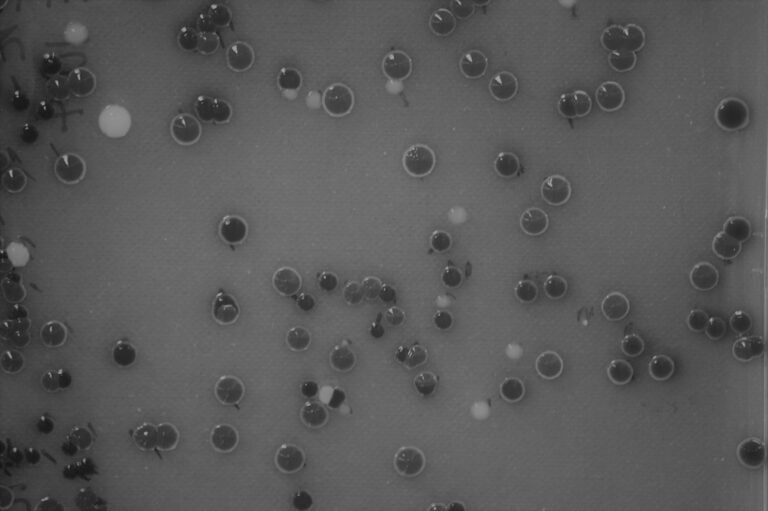

Project Description
Bacteriophages are viruses which infect bacteria. They are the most numerous organisms in all of earth’s ecosystems, outnumbering their bacterial hosts by approximately ten to one. Bacteriophages are thought to be major regulators of bacterial density and activity, and consequently an important determinant of the role bacteria play in biochemical cycles. But bacteriophages are not a homogenous group of organisms – there is a huge amount of phenotypic and genotypic variation between different bacteriophages. In particular, the rapid increase in sequenced bacteriophage genomes over the previous decade has revealed a remarkable amount of genetic diversity. This is true for the content of bacteriophage genomes, but also more fundamentally the size of bacteriophage genomes – bacteriophages are known to vary from fewer than ten genes to almost eight hundred genes. The ecological implications of this variation in genome size remains unknown. Whether larger phages represent an alternative ecological strategy with different life-history traits and different biogeography is unclear, as they could represent an alternative way of filling the same ecological niche with the same biogeography.
This exciting project will involve a mixture of laboratory work and environmental meta-genomics to address questions such as:
- Do different environments favour phages of different size?
- Do phages of different size impact their host in different ways?
- Do phages of different size have different ecological strategies and life history traits?
- Does the extremeness of an environment limit a bacteriophage’s (i) physical size, (ii) genome size, and (iii) the ratio of genome to physical size?
This studentship will be based in the School of Biological Sciences at the University of Aberdeen under the lead supervision of Dr Tom Vogwill, and co -supervised by Dr Julianne Megaw (Queen’s University Belfast) and Dr Ashish Malik (University of Aberdeen). The supervision team has expertise spanning bacteriophages, bacteria, and archaea, and employ a wide range of experimental techniques including experimental evolution, molecular biology, bioinformatics, and meta-genomics. Full training will be provided in all techniques relevant to the project. The ideal student would be self-motivated with either an MSc or a BSc in evolutionary biology, microbiology, or ecology, and an enthusiasm for addressing fundamental questions about micro-organisms.
CANDIDATE BACKGROUND
Essential skills:
- A good undergraduate degree in biological sciences
- An interest in the ecology and evolution of micro-organisms
Desirable skills:
- A postgraduate degree in microbiology/ecology/evolutionary biology
- Microbiology laboratory experience
- Molecular biology laboratory experience
- Experience handling environmental samples
- Bioinformatic experience
Photo credit: Thomas Vogwill
Supervisors
Thomas VogwillPrimary Supervisor: | Profile: Thomas Vogwill Email: thomas.vogwill@abdn.ac.uk Institution: University of Aberdeen Department/School: School of Biological Sciences |
Julianne MegawSecondary Supervisor: | Profile: Julianne Megaw Email: j.megaw@qub.ac.uk Institution: Queen's University, Belfast Department/School: School of Biological Sciences |
Ashish MalikPrimary Supervisor: | Profile: Ashish Malik Email: ashish.malik@abdn.ac.uk Institution: University of Aberdeen Department/School: School of Biological Sciences |
QUADRAT Themes
- biodiversity